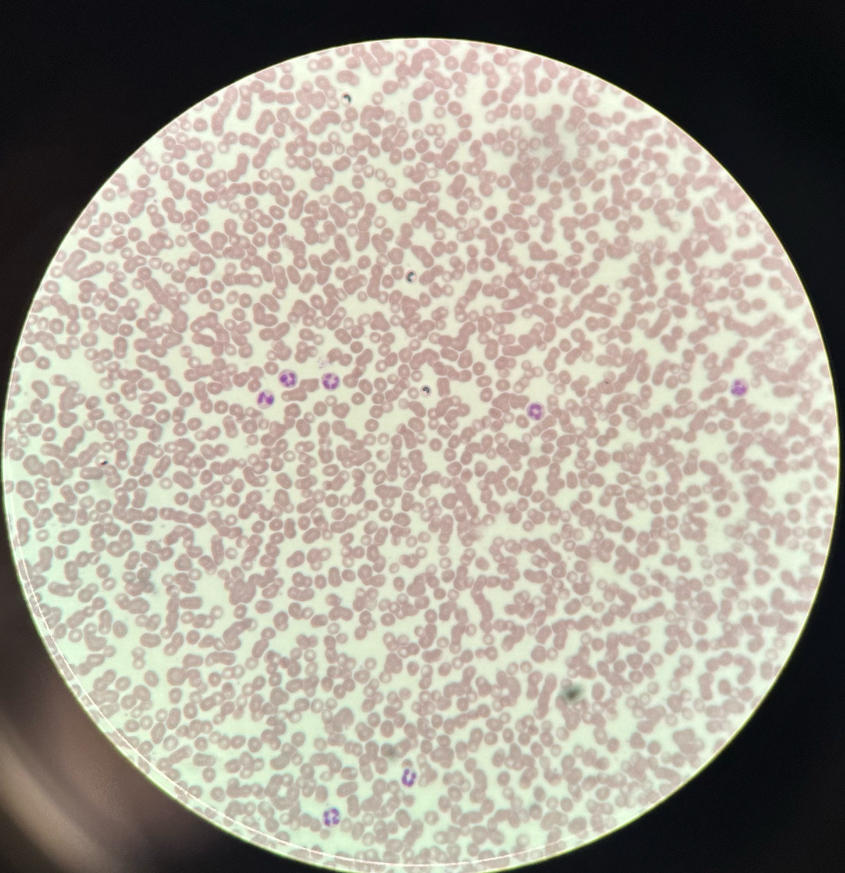
<p></p>
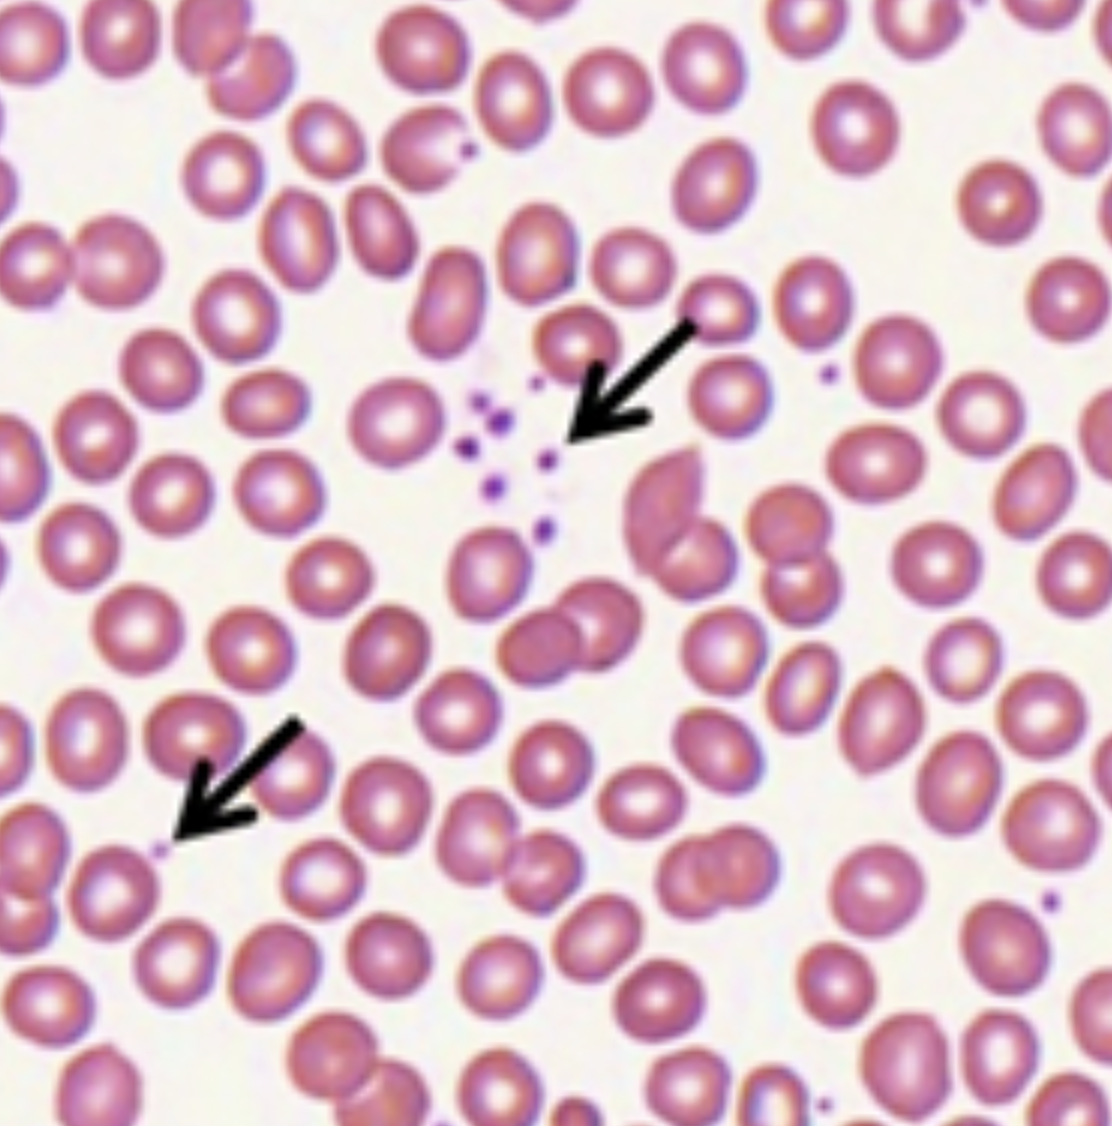
knowt flashcard image
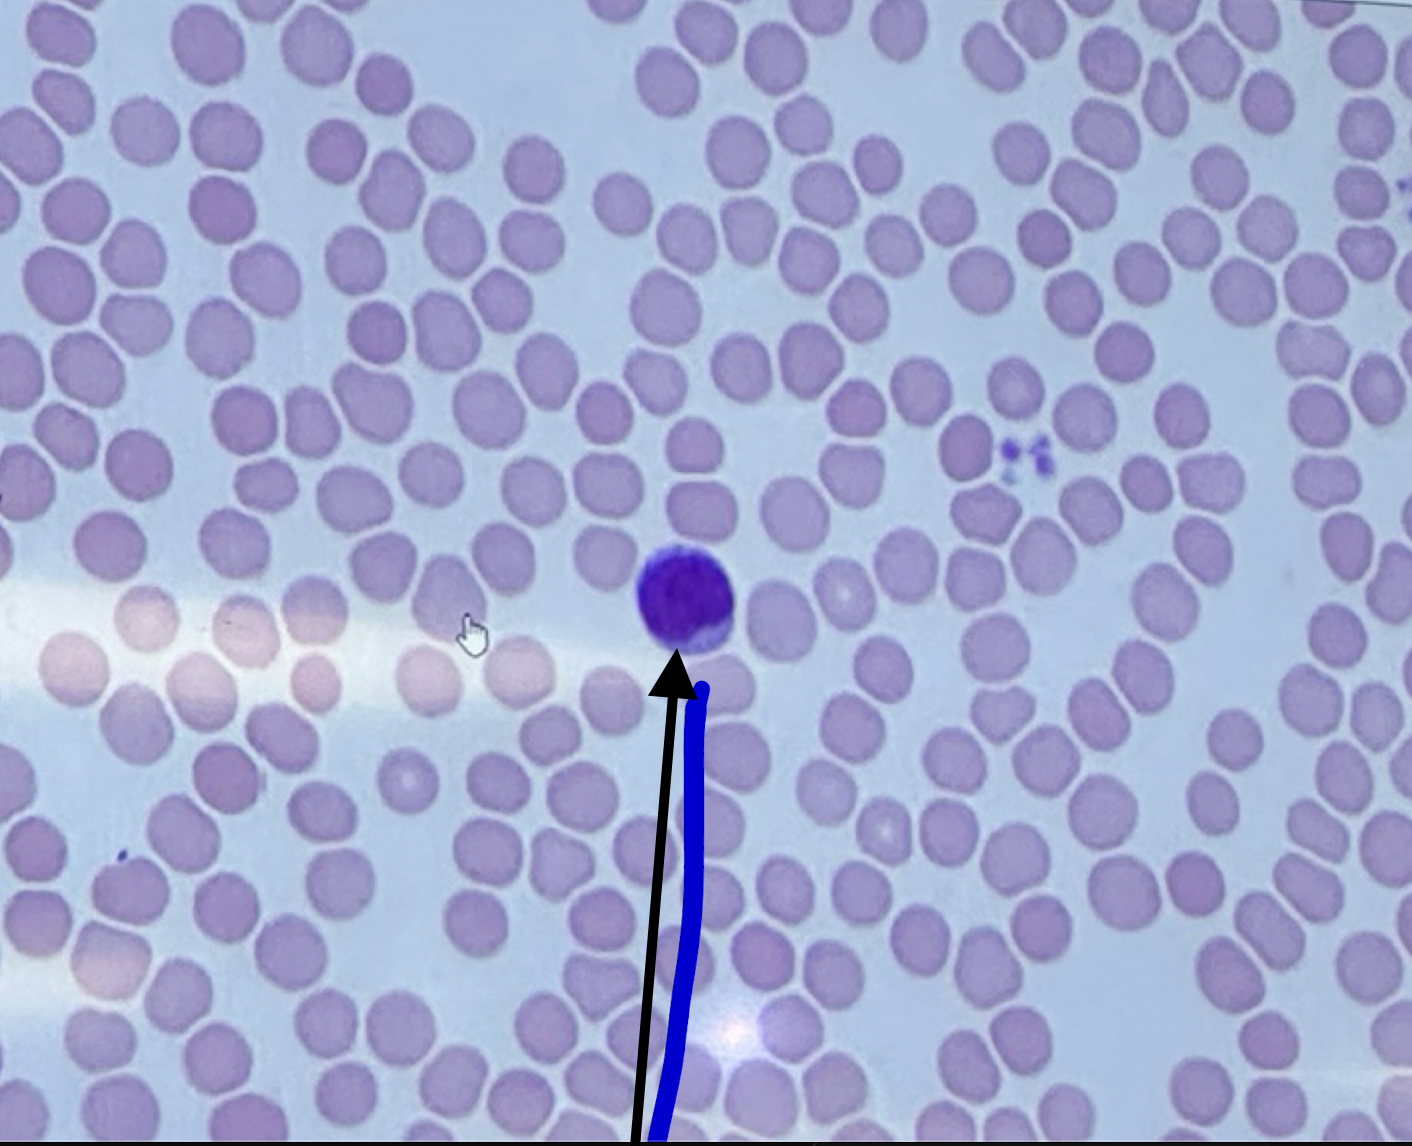
<p></p>
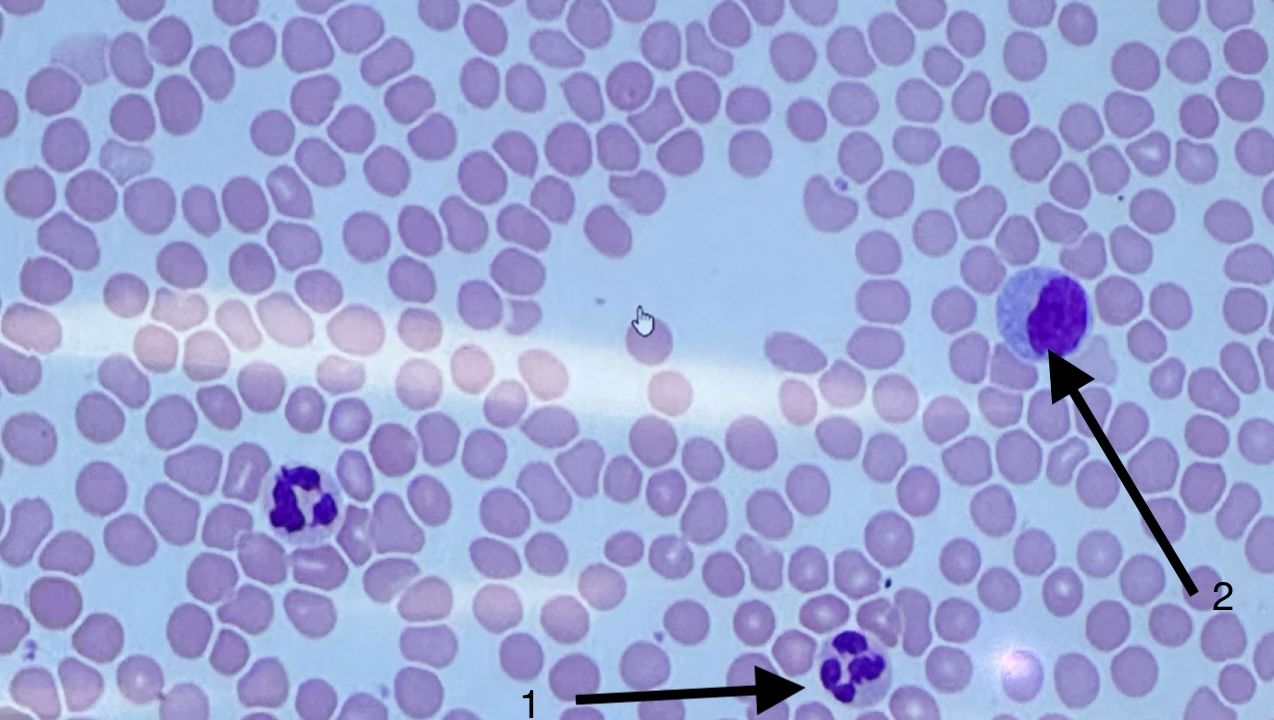
<p>2</p>

1/35
Looks like no tags are added yet.
Name | Mastery | Learn | Test | Matching | Spaced | Call with Kai |
|---|
No analytics yet
Send a link to your students to track their progress
blood
erythrocytes
2

platelets
neutrophils
1

lymphocytes
monocytes
2
cardiac muscle
slide

cardiocyte
whole thing

nucleus
2

intercalated disc
1

artery slide

artery - tunica intima
2

artery - tunica media
3

artery - tunica adventitia
4

vein - slide

vein - tunica intima
1

vein - tunica media
2

vein - tunica adventitia
3

trachea
slide

psuedostratified ciliated columnar epithelium
1

lamina propria
2

tunica submucosa
3

tracheal cartilage
4

trachealis muscle

tunica adventitia
5

lungs
slide

alveoli
1

bronchiole
2

lymph node
slide

capsule
1

cortex
2

medulla
3

spleen
slide

capsule
1

red pulp
2

white pulp
3
